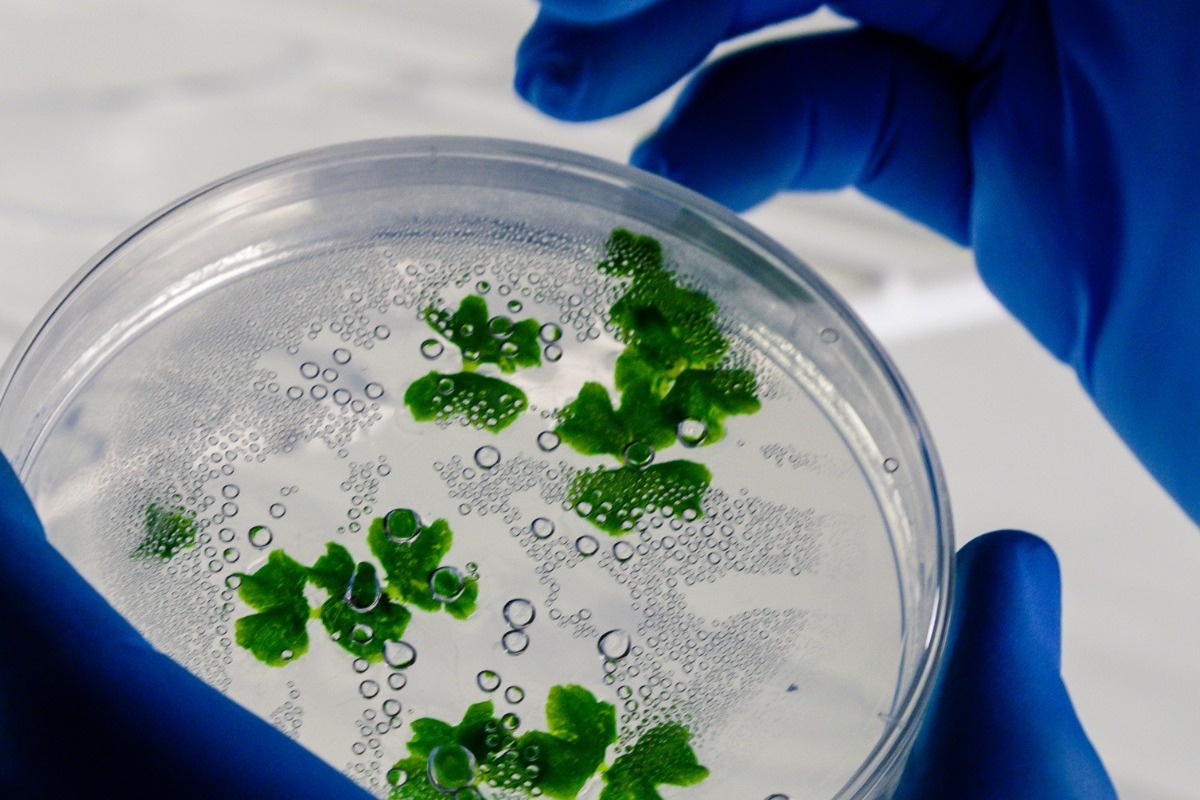
Οι επιστήμονες χτυπούν το «καμπανάκι» – Δύο νέοι ιοί η επόμενη μεγάλη απειλή

Οι επιστήμονες χτυπούν το «καμπανάκι» – Δύο νέοι ιοί η επόμενη μεγάλη απειλή
Το κύριο πρόβλημα είναι ότι οι ιοί με ζωική προέλευση μπορούν να μεταλλαχθούν
Δημοσίευση 31/1/2026 | 09:46
Ένα νέο ανησυχητικό δημοσίευμα από διεθνές ιατρικό site επισημαίνει ότι δύο αναδυόμενοι ιοί με ζωική προέλευση – που μέχρι τώρα «κρατούνται σε ησυχία» – ενδέχεται να αποτελέσουν μελλοντικές απειλές για τη δημόσια υγεία, εάν δεν ενισχυθούν η παρακολούθηση, η διάγνωση και η προετοιμασία αντιμέτρων.
Σύμφωνα με το Medical Xpress, επιστήμονες που μελετούν νέους παθογόνους ιούς αναφέρουν ιδιαίτερη προσοχή σε δύο: τον ιό της γρίπης D και έναν σκυλοκορονοϊό (canine coronavirus). Αυτοί οι ιοί μέχρι τώρα έχουν περιορισμένη επίπτωση στον άνθρωπο, αλλά έχουν όλα τα χαρακτηριστικά που θα μπορούσαν να τους κάνουν να εξαπλωθούν ευρύτερα στο ανθρώπινο πληθυσμό, εάν αποκτήσουν την ικανότητα να μεταδίδονται εύκολα από άνθρωπο σε άνθρωπο.
Οι ειδικοί τονίζουν ότι έως τώρα οι περισσότερες μολύνσεις από τον ιό γρίπης D ήταν ασυμπτωματικές και παρατηρήθηκαν κυρίως σε υπαλλήλους ζωοτεχνικών μονάδων, όμως αυτό δεν πρέπει να εφησυχάζει τους επιστήμονες. Το κύριο πρόβλημα είναι ότι οι ιοί με ζωική προέλευση μπορούν να μεταλλαχθούν και να αποκτήσουν νέα χαρακτηριστικά που διευκολύνουν τη μετάδοση στον άνθρωπο.
Ο σκυλοκορονοϊός, από την άλλη, έχει ήδη σχετιστεί με ανθρώπινες λοιμώξεις, αλλά η συχνότητα και η έκταση των μολύνσεων είναι δύσκολο να εκτιμηθούν, επειδή δεν γίνονται τακτικά σχετικές διαγνωστικές εξετάσεις. Οι επιστήμονες τονίζουν ότι χωρίς συστηματική παρακολούθηση και αξιόπιστες δοκιμές, δεν υπάρχει τρόπος να γνωρίζουμε πόσο ευρύ είναι το «αόρατο φορτίο» αυτών των ιών στον πληθυσμό.
Το μήνυμα των ειδικών είναι σαφές: η προετοιμασία για το επόμενο πιθανό «κύμα» λοιμώξεων δεν πρέπει να περιμένει μέχρι να ξεσπάσει μια νέα επιδημία. Χρειάζεται ενίσχυση της επιδημιολογικής επιτήρησης, βελτίωση των ελέγχων, ανάπτυξη αξιόπιστων τεστ και επένδυση σε πιθανά εμβόλια και θεραπείες.
Η πρόκληση που θέτουν αυτοί οι αναδυόμενοι ιοί υπενθυμίζει ότι η παρακολούθηση της ζωικής υγείας και η πρόληψη πριν από την εμφάνιση συμπτωμάτων είναι κρίσιμη — μια προσέγγιση που απαιτεί συνεργασία μεταξύ ιατρικής, κτηνιατρικής και περιβαλλοντικών επιστημών, γνωστή και ως One Health.
Αυτή η νέα έρευνα δείχνει ότι η επόμενη μεγάλη απειλή για την παγκόσμια υγεία μπορεί ήδη να «κυκλοφορεί» χωρίς να το γνωρίζουμε πλήρως, και η ετοιμότητα σήμερα μπορεί να αποτρέψει το αύριο.












